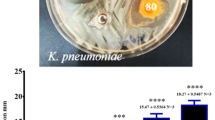

Abstract
SINCE Kinosita1 first showed that rats developed malignant tumours of the liver when fed a deficient diet containing N,N-dimethyl-p-aminoazobenzene (butter-yellow), much work has been done in an attempt to elucidate the mechanism whereby this azo-dye brings about neoplastic changes in liver tissue. One aspect studied has been the metabolism of the dye itself; Stevenson, Dobriner and Rhoads2 were able to isolate p-aminophenol and p-phenylenediamine, and also their N-acetylation products, from the urine of rats receiving the dye orally. Thus the azo-link is split as in the case of o-aminoazotoluene3 and other azo-compounds in the animal body. However, the absence of N,N-dimethyl-p-phenylene-diamine from fractions prepared without addition of sodium hydrosulphite suggested that complete demethylation occurs at some stage prior to the acetylation of the p-phenylenediamine. This lability of the N-methyl groups has been neatly demonstrated by Jacobi and Baumann4, who found butter-yellow could function like other methyl-donors in protecting young rats against kidney lesions when on a choline-free diet.
This is a preview of subscription content, access via your institution
Access options
Subscribe to this journal
Receive 51 print issues and online access
$199.00 per year
only $3.90 per issue
Buy this article
- Purchase on SpringerLink
- Instant access to full article PDF
Prices may be subject to local taxes which are calculated during checkout
Similar content being viewed by others
References
Kinosita, Trans. Jap. Path. Soc., 27, 665 (1937).
Stevenson, Dobriner and Rhoads, Cancer Res., 2, 160 (1942).
Hashimoto, Gann., 29, 306 (1935).
Jacobi and Baumann, Cancer Res., 2, 175 (1942).
Kensler, Dexter and Rhoads, Cancer Res., 2, 1 (1942).
Law, Cancer Res., 1, 397 (1941).
Miller, Miner, Rusch and Baumann, Cancer Res., 1, 699 (1941).
Kensler, Young and Rhoads, J. Biol. Chem., 143, 465 (1942).
Potter, Cancer Res., 2, 688 (1942).
Author information
Authors and Affiliations
Rights and permissions
About this article
Cite this article
KIRBY, A. Carcinogenic Effect of Aminoazobenzene. Nature 154, 668–669 (1944). https://doi.org/10.1038/154668a0
Issue date:
DOI: https://doi.org/10.1038/154668a0
This article is cited by
-
Sex differences in the excretion of O-aminoazotoluene by mice
Bulletin of Experimental Biology and Medicine (1964)